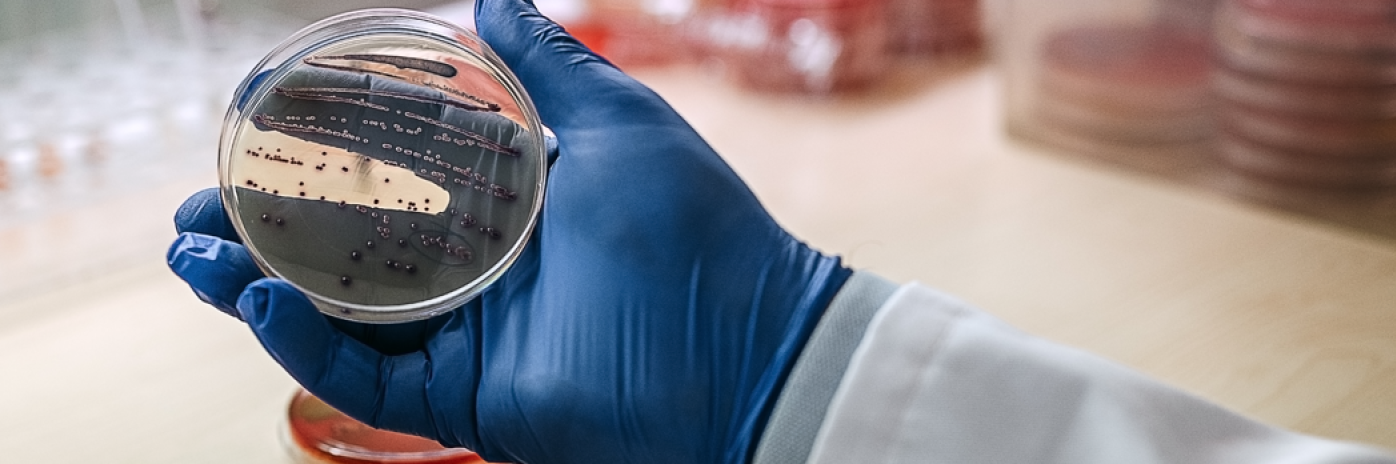

Food & Health, il futuro alimentare nasce dal passato
«Siamo ciò che mangiamo», diceva il filosofo tedesco Ludwig Feuerbach, convinto che la longevità di un popolo passasse dalla sua alimentazione. Un concetto che oggi è centrale in molte discipline scientifiche e che è alla base anche di uno dei nostri settori tecnologici: Food & Health. Un’area di ricerca, sviluppo e trasferimento tecnologico, che crea ponti tra laboratori e aziende e che dopo essere nata con un focus specifico sul cibo, si è ora espansa abbracciando anche il comparto salute.
«Il tema della "sana alimentazione" è ovunque. Per le persone è sempre più importante mangiare in modo sano e capire quale influenza un alimento può avere sul benessere e sulla salute. Con il nostro lavoro, vogliamo provare a dare delle risposte a queste domande e, insieme ai metodi biomedici, ampliare la comprensione dell'interazione tra nutrizione e salute, rendendola accessibile alle aziende. Per questo motivo, il settore tecnologico è diventato "Food & Health", con le aree di interesse materie prime & by-products, Optimal Processing & Fermentation e Omics & Precision Health. In questo modo, la nostra strategia copre l'intero ciclo del valore: dalle materie prime ai processi fino all'effetto sul corpo umano, valorizzando il know-how e i laboratori dei partner del parco» ha spiegato Matthias Fill, head of Tech Transfer Food & Health.
Uno dei primi passi di questa strategia è stata la conferenza Human Microbiome Symposium che lo scorso 24 maggio ha riunito i principali partner del progetto e quasi 100 persone intervenute nel pubblico. «Abbiamo voluto parlare del microbioma umano perché ha un ruolo centrale nella salute umana: si tratta infatti dei microorganismi, del loro patrimonio genetico e delle interazioni ambientali; per farsi un’idea di quanto sono presenti nel nostro corpo, basti pensare che superano il numero delle nostre cellule. Dieta, microorganismi e altri fattori interagiscono nel nostro corpo influenzando la nostra salute: per tutelarla, al NOI Techpark studiamo questa interazione da diversi punti di vista. Per esempio: quello che mangi, ha effetto sui microorganismi, e a cascata sulla digestione e quindi sullo stato della nostra salute. Il microbioma umano è un tema così ampio che la ricerca può essere portata avanti solo attraverso la cooperazione interdisciplinare tra diversi partner. Il NOI ha numerose competenze in questo settore e sta mettendosi in rete a livello nazionale e internazionale con esperti ed esperte per elaborare soluzioni per il futuro: questo simposio è il punto di partenza» ha aggiunto Sandra Fleischmann, Subject Matter Expert per Optimal Processing & Fermentation di NOI Techpark, ricordando che l’obiettivo di un evento come il Symposium è proprio quello di mettere in rete le aziende e le voci della ricerca, affinché possano nascere nuove collaborazioni orientate all’innovazione.

Nello specifico, l’area di specializzazione materie prime & by-products parte dal presupposto che per realizzare alimenti di qualità bisogna avere ingredienti di qualità.
L'attenzione si concentra principalmente sulla lavorazione delle materie primarie e secondarie in modo olistico. Dove ciò non è possibile, si lavora estraendo, analizzando e stabilizzando le sostanze bioattive dai sottoprodotti, ed è così possibile sviluppare nuove formulazioni di prodotti di alta qualità. Con il tema Optimal Processing & Fermentation, invece, si segue il modo in cui le materie primarie e secondarie e gli ingredienti vengono conservati e lavorati. Il focus è quindi sui processi che attivano le proprietà organolettiche e salutari degli alimenti, a partire dalla fermentazione, un antico metodo di conservazione che sta diventando sempre più importante anche per la moderna industria alimentare. Lo dimostra il "Centro Internazionale sulle fermentazioni degli alimenti" che arriverà qui al NOI Techpark: sarà un luogo in cui le aziende lavoreranno con la piattaforma Micro4Food su progetti a lungo termine. Tutto questo, va di pari passo con l'area Omics & Precision Health, che da un lato è dedicata ai metodi biotecnologici che stanno diventando sempre più importanti nel settore alimentare e, dall'altro, guarda alla salute in modo olistico. Un'alimentazione sana, infatti, può migliorare la salute, ma è solo un pezzo del puzzle. Sulla base delle competenze chiave dell'Istituto di biomedicina di Eurac Research, svilupperemo servizi e soluzioni per la cosiddetta "salute di precisione". Queste tecnologie ci permettono, infatti, di comprendere meglio l'influenza del cibo sulla salute umana e costituiscono al contempo il nucleo di nuove attività e idee commerciali nel campo della prevenzione delle malattie.

E anche i ricercatori e le ricercatrici di Eurac Research e unibz, partner del NOI, hanno condiviso riflessioni e progetti sul tema Food & Health. Frank Maixner, dell’Istituto per lo studio delle mummie di Eurac Research, ha spiegato: «Le mummie sono delle vere e proprie istantanee dell’antichità in grado di aiutarci a comprendere meglio il presente. Qui a Bolzano abbiamo Ötzi, ma in giro per il mondo ce ne sono molte altre che appartengono a epoche diverse: attraverso la ricerca su questo tipo di resti è possibile conoscere la storia delle varie popolazioni e comprendere l’evoluzione degli eventi patogeni e la conservazione». Un ambito fondamentale anche per l’innovazione Food & Health.
«Noi invece studiamo come il patrimonio genetico, l’ambiente in cui viviamo e lo stile di vita influiscono sulla comparsa e lo sviluppo delle malattie e sulla salute delle persone» - ha aggiunto Christian Fuchsberger, dell’Istituto di biomedicina di Eurac Research. «Nello specifico, abbiamo condotto uno studio genetico in Val Venosta che ha mostrato in maniera evidente l’enorme influenza del microbioma sulla salute umana. In seguito a ulteriori ricerche, sempre più precise, abbiamo osservato i mutamenti del microbioma a seconda dei diversi tipi di dieta – onnivora, vegetariana e vegana – e del consumo di alcool e fumo».

Olga Nikoloudaki della Libera Università di Bolzano, ricercatrice del team del professor Marco Gobbetti, a sua volta, ha evidenziato come la dieta o i probiotici influenzino la composizione e la funzionalità del microbiota intestinale. Gli studi a riguardo sono stati svolti con SHIME (Simulator of the Human Intestinal Microbial Ecosystem), un dispositivo che simula il processo digestivo umano, unico in Italia, installato nella piattaforma di laboratori Micro4Food della Libera Università di Bolzano al NOI Techpark. La piattaforma Micro4Food, infatti, con i suoi sei laboratori complementari e i tre impianti pilota, studia la trasformazione del cibo, utilizzando i vantaggi offerti dalla fermentazione per migliorare le proprietà nutrizionali, funzionali, organolettiche e di conservabilità degli alimenti. Il tutto, ricorrendo a nuovi processi e prodotti e utilizzando rifiuti e sottoprodotti della catena alimentare. «Lo SHIME simula in vitro la digestione gastrointestinale umana in condizioni controllate. In questo modo è possibile studiare l'effetto dell'alimento/dieta sull'evoluzione del microbiota intestinale e sui rispettivi metaboliti» - ha chiarito Nikoloudaki, che ha continuato: «SHIME è composto da cinque bioreattori che simulano i vari tratti dell’apparato digerente: dallo stomaco al piccolo intestino fino alle tre regioni del colon. Attraverso un pannello computerizzato è possibile controllare la temperatura e altri parametri del processo digestivo, così da capire come si evolve la comunità microbica e il microbiota intestinale e come questi cambiano in funzione di un determinato stimolo, sia esso un alimento o un nutriente specifico».
Cosa dice tutto questo rispetto agli alimenti? «Il sistema permette sia di verificare come un particolare alimento viene digerito sia di osservarne l'effetto sulla composizione batterica, attraverso l’identificazione dei microrganismi presenti» - ha specificato la ricercatrice. «Si tratta di un procedimento che richiede diversi step: il campione viene prima estratto dalle cellule microbiche e successivamente amplificato, creando così tante copie dei segmenti di DNA di nostro interesse. A questo punto il DNA viene sequenziato e confrontato con sequenze presenti in banche dati».
Ricerca e innovazione possono essere quindi, mai come oggi, alleati strategici del benessere umano. Con un contributo prezioso che arriva anche dalla preistoria.
Qui puoi scoprire di più su questo servizio.
